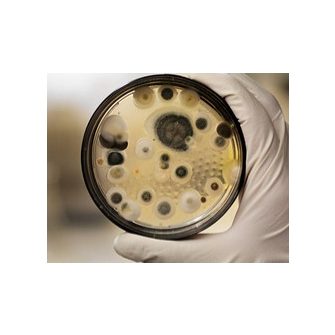
Gomba ellen

Mire keresel megoldást?
Figyelmeztetés! Az étrend-kiegészítők nem gyógyszerek, nem rendelkeznek gyógyhatással, nem alkalmasak betegségek kezelésére, sem megelőzésére. Az étrend-kiegészítők élelmiszerek, így a jelölésükre (címkefeliratok, a címkén, csomagoláson található bármely jel, ábra stb.) és reklámozásukra az élelmiszereknél megfogalmazott általános előírásokat kell alkalmazni. Ennek megfelelően a termékek jelölése, megjelenítése és hirdetése nem állíthatja vagy sugallhatja, hogy az étrend-kiegészítő betegségek megelőzésére, kezelésére alkalmas, vagy ilyen tulajdonsága van. Kérjük, a gyártók leírásainak és reklámjainak olvasásakor ezt vedd figyelembe!